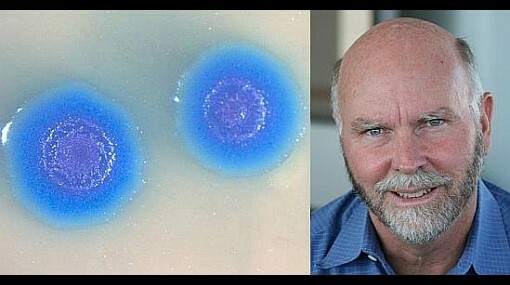
Célula Artifical

-
 Robert Hook fue un físico y astrónomo logro en 1665 descubrir las células, utilizando un microscopio de doble lente logra observar en un corcho ya que estaba compuesto por celdas iguales
Robert Hook fue un físico y astrónomo logro en 1665 descubrir las células, utilizando un microscopio de doble lente logra observar en un corcho ya que estaba compuesto por celdas iguales -
 Un científico británico llamado Robert Brown descubre en 1831 el núcleo celular, esto ocurre después de analizar una célula vegetal, este científico piensa que el núcleo está presente en todas las células, ya que , no se da cuenta que solo las células eucariotas lo tienen
Un científico británico llamado Robert Brown descubre en 1831 el núcleo celular, esto ocurre después de analizar una célula vegetal, este científico piensa que el núcleo está presente en todas las células, ya que , no se da cuenta que solo las células eucariotas lo tienen -
 Entre 1838 y 1839 se crea la teoría celular propuesta por Matthias Jakob Schleiden y Theodor Schwann esta teoría dice que todos los organismos están compuestos de células, la unidad básica de la vida es la célula y que toda célula proviene de otra célula
Entre 1838 y 1839 se crea la teoría celular propuesta por Matthias Jakob Schleiden y Theodor Schwann esta teoría dice que todos los organismos están compuestos de células, la unidad básica de la vida es la célula y que toda célula proviene de otra célula -
 En 1869 un biólogo de procedencia sueca llamado Johann Friedrich Miescher, a partir del pus de vendajes quirúrgicos y de las células que estaban presentes ahí separo los núcleos y comprobó que en estos había una sustancia química a la que denomino "NUCLEINA"(ÁCIDOS NUCLEICOS).
En 1869 un biólogo de procedencia sueca llamado Johann Friedrich Miescher, a partir del pus de vendajes quirúrgicos y de las células que estaban presentes ahí separo los núcleos y comprobó que en estos había una sustancia química a la que denomino "NUCLEINA"(ÁCIDOS NUCLEICOS). -
 El botánico suizo Albert von Kolliker observa entre 1880 y 1885 unos gránulos en las células musculares, identificándolas como mitocondrias
El botánico suizo Albert von Kolliker observa entre 1880 y 1885 unos gránulos en las células musculares, identificándolas como mitocondrias -
 Ludwig Karl Martin Leonhard Albrecht Kossel
Ludwig Karl Martin Leonhard Albrecht Kossel
Es un químico alemán que en 1888 hizo un descubrimiento a partir de la nucleína ya que logra descifrar la química de esta, encontrando proteínas. -
 Theodor Boveri y Walter Sutton
Theodor Boveri y Walter Sutton
Estos científicos desarrollan la teoría cromosómica de la herencia en 1902, esta teoría estudia los genes, afirmando que estos se encuentran dentro de el núcleo en forma de cromosomas, con esto se logro entender que ciertas características se heredan y otras no -
 En 1930 el biólogo alemán Joachim Hammerling declara que el núcleo es el encargado de las características esto gracias al experimento que llevo acabo determinando que el núcleo produce una sustancia que controla las características de la célula
En 1930 el biólogo alemán Joachim Hammerling declara que el núcleo es el encargado de las características esto gracias al experimento que llevo acabo determinando que el núcleo produce una sustancia que controla las características de la célula -
 En 1938 un matemático llamado Warren Weaver fue el primero en utilizar el término biología molecular
En 1938 un matemático llamado Warren Weaver fue el primero en utilizar el término biología molecular -
 El físico Francis Crick en 1958 publica un trabajo donde habla sobre como se sintetizan las proteínas y postulando una hipótesis la cual nombra “dogma central de la biología molecular”
El físico Francis Crick en 1958 publica un trabajo donde habla sobre como se sintetizan las proteínas y postulando una hipótesis la cual nombra “dogma central de la biología molecular” -
 En 1982 a través de la colaboración de dos investigadores llamados Richard Palmiter y Ralph Brinster se da el nacimiento del primer ratón transgénico, para lograr esto inyectaron un gen modificado de la hormona del crecimiento, dando como resultado un roedor que creció a un ritmo apresurado hasta hacerse gigante
En 1982 a través de la colaboración de dos investigadores llamados Richard Palmiter y Ralph Brinster se da el nacimiento del primer ratón transgénico, para lograr esto inyectaron un gen modificado de la hormona del crecimiento, dando como resultado un roedor que creció a un ritmo apresurado hasta hacerse gigante -
 La primera planta genéticamente modificada fue creada en 1986, esto fue realizado en una planta de tabaco, a esta se la añadió un gen de resistencia a la Kanamicina
La primera planta genéticamente modificada fue creada en 1986, esto fue realizado en una planta de tabaco, a esta se la añadió un gen de resistencia a la Kanamicina -
 En 1997 Ian Wilmut un embriologísta británico consigue el primer organismo clonado, obteniendo así a la oveja Dolly quien nace como resultado de una ubre de su madre y de otra oveja utilizan un ovulo, al cual se le extrajo el material genético. Por último fusionaron el ovulo sin núcleo con el núcleo de la célula mamaria
En 1997 Ian Wilmut un embriologísta británico consigue el primer organismo clonado, obteniendo así a la oveja Dolly quien nace como resultado de una ubre de su madre y de otra oveja utilizan un ovulo, al cual se le extrajo el material genético. Por último fusionaron el ovulo sin núcleo con el núcleo de la célula mamaria -
En 2008 Craig Venter un biólogo estadounidense logro fabricar en un laboratorio por primera vez una célula artificial
En 2008 Craig Venter un biólogo estadounidense logro fabricar en un laboratorio por primera vez una célula artificial
Plan projects on a visual timeline
Map milestones, phases, deadlines, and key events in one place so the sequence is easier to see and share. Timetoast is a timeline maker for work, school, research, and stories.
